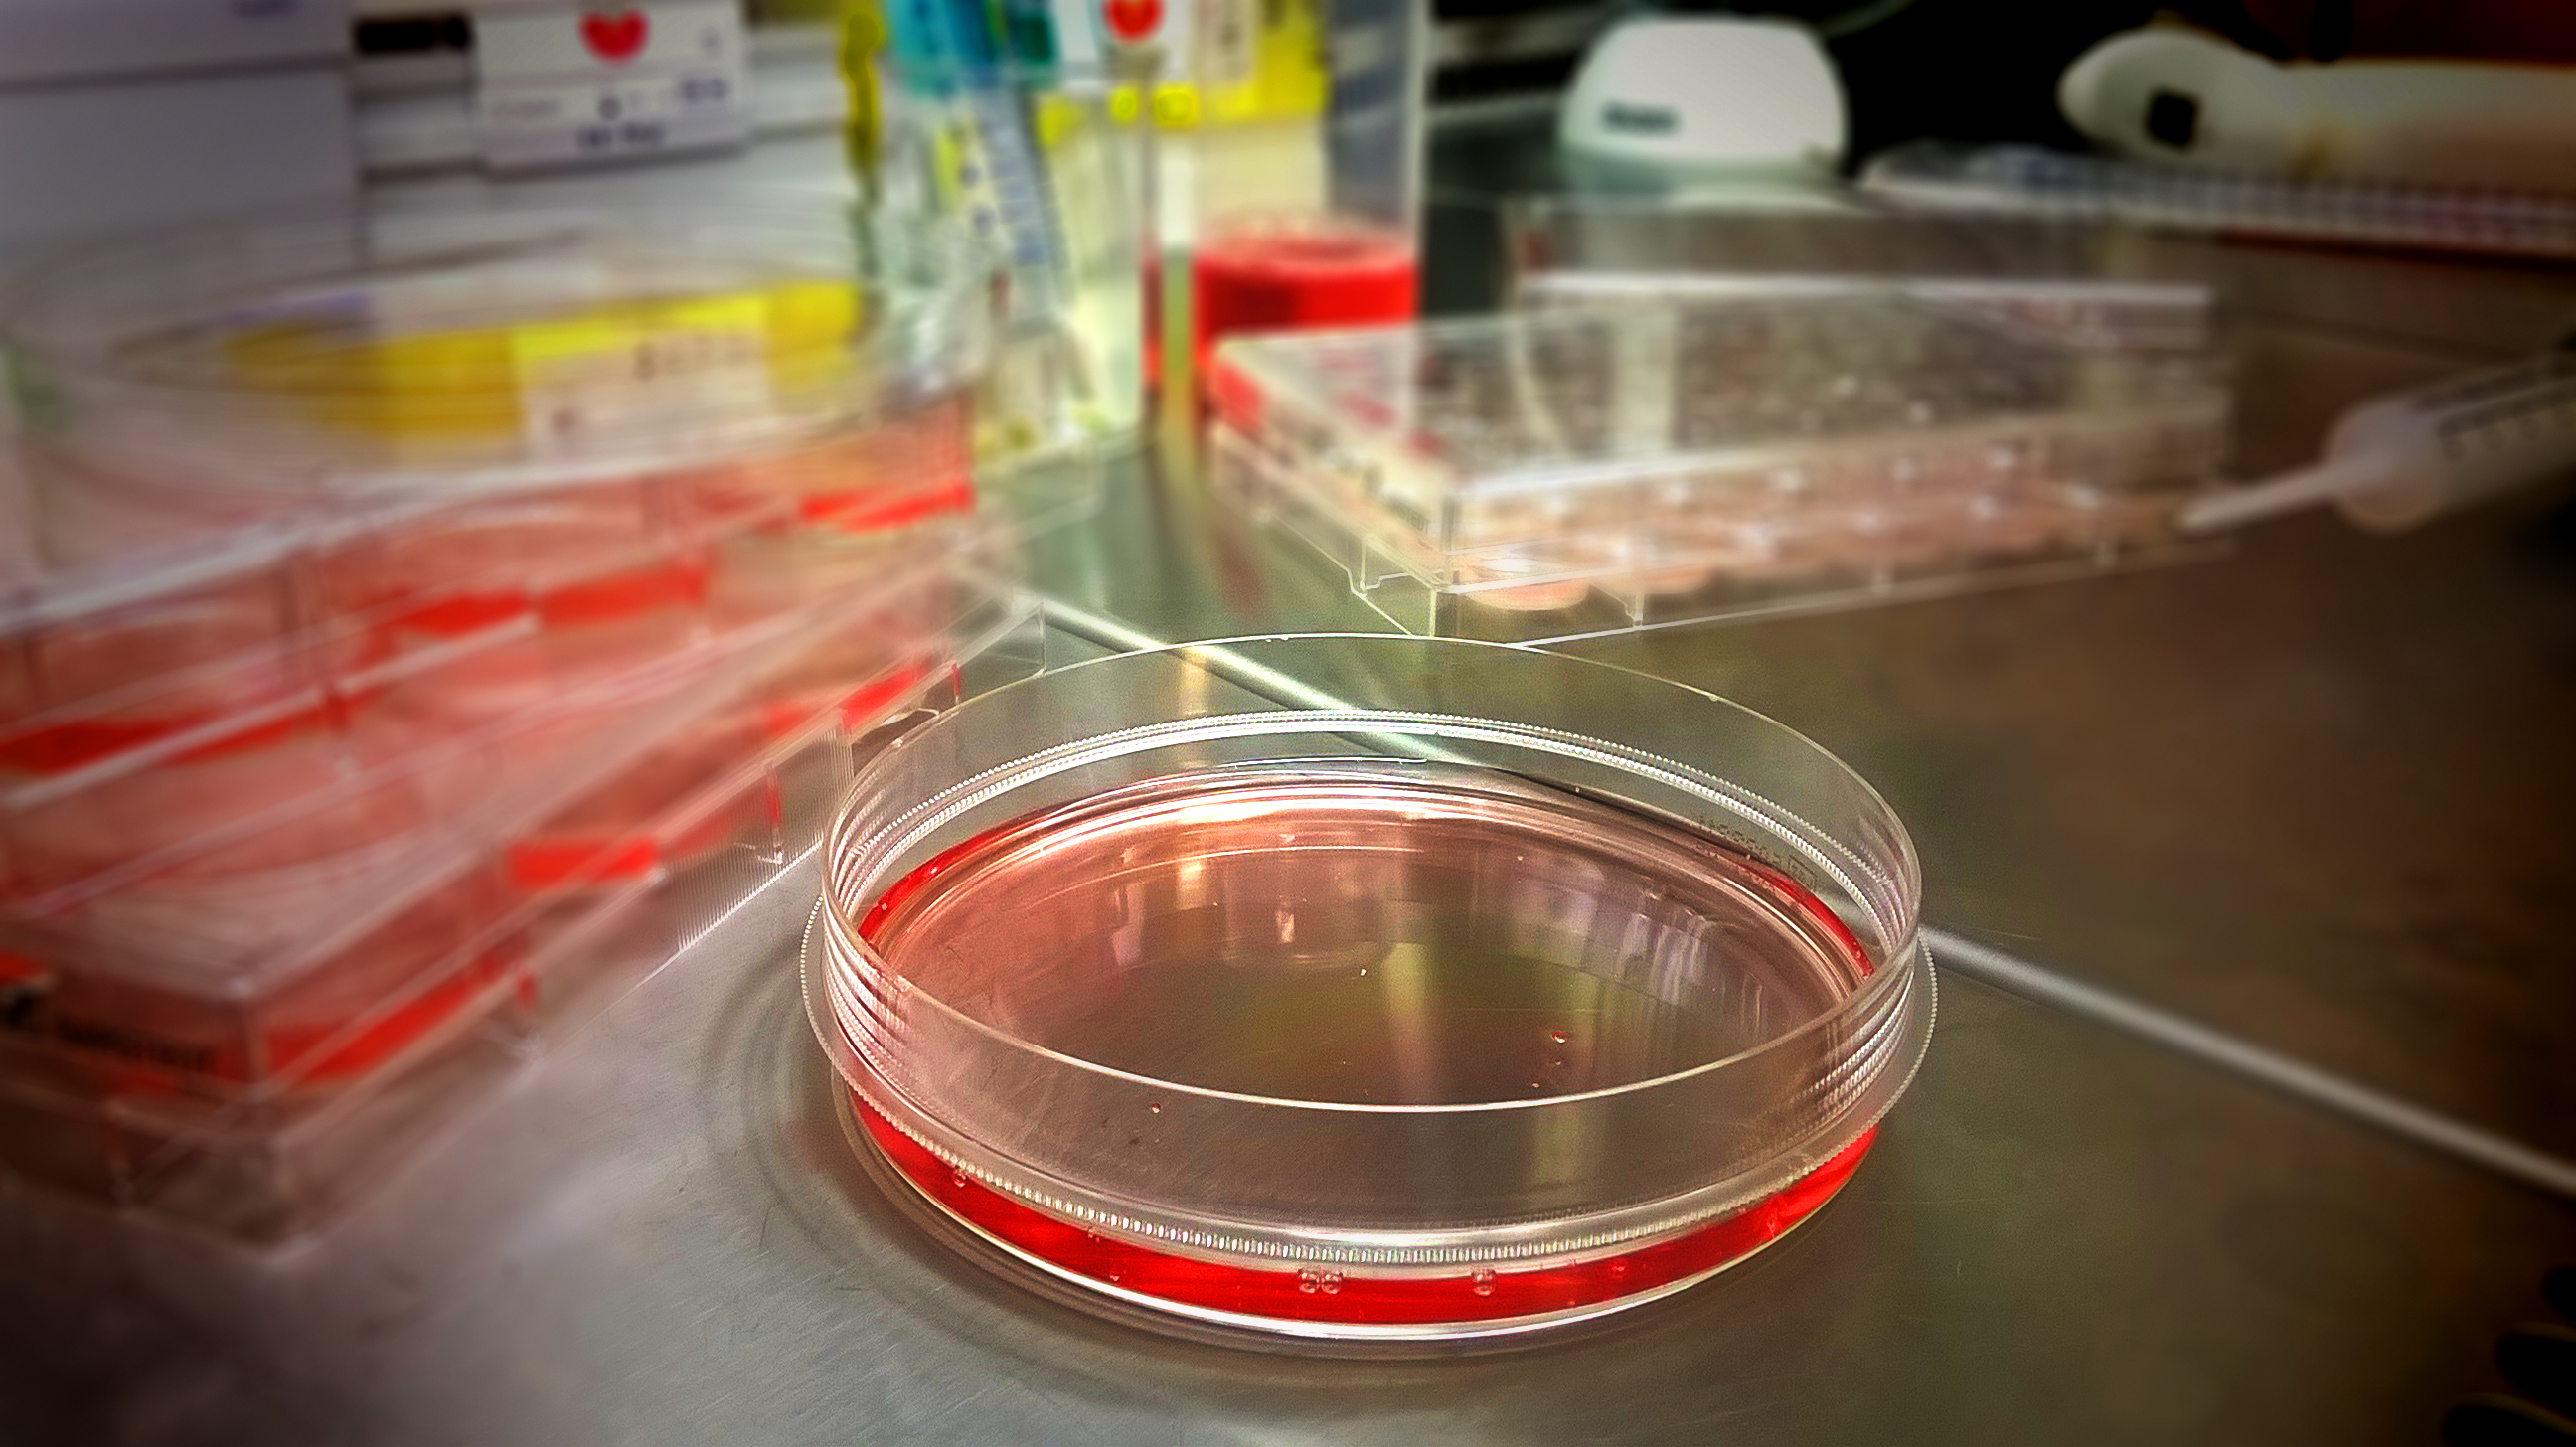
Projekty i granty.

Identyfikacja szlaku metabolomicznego proliny jako molekularnego celu eksperymentalnej regulacji apoptozy/autofagii w komórkach raka sutka MCF-7 (N/NCN/OP/15/002/2214), Uniwersytet Medyczny w Białymstoku
Przedmiotem projektu badawczego była ocena roli metabolizmu proliny w regulacji apoptozy/autofagii w komórce nowotworowej MCF-7 w celu identyfikacji molekularnego celu potencjalnej farmakoterapii raka piersi. Uwagę skupiono na mitochondrialnej dehydrogenazie prolinowej/oksydazie prolinowej (PRODH/POX), jedynym enzymie uczestniczącym w degradacji proliny; prolidazie, cytoplazmatycznym enzymie dostarczającym wolną prolinę do procesów metabolicznych; oraz biosyntezie kolagenu, procesie utylizującym ten aminokwas. Wiadomo, że degradacja proliny przez PRODH/POX przyczynia się do produkcji ATP sprzyjając autofagii (procesom pro-przeżyciowym) lub ROS indukujących apoptozę. Z uwagi na brak wiedzy na temat mechanizmu przełączania apoptozy/autofagii przedstawiono hipotezę regulacji tego procesu. Podłoże tej hipotezy stanowi kompleksowa regulacja metabolizmu proliny, głównie z udziałem prolidazy, PRODH/POX i biosyntezy kolagenu, które mogą stanowić interfejs apoptozy/autofagii. Weryfikację założeń przeprowadzono na modelu in vitro z użyciem komórek raka sutka MCF-7 wild-type oraz z konstytutywnie wyciszoną ekspresją PRODH/POX przy użyciu komplementarnego fragmentu shRNA tego genu (MCF-7shPRODH/POX), zgłoszenie patentowe nr P.421954.
W modelu tym zbadano wpływ wewnątrzkomórkowej dostępności proliny na PRODH/POX-zależną apoptozę. Wyniki badań świadczą o potencjalnie ważnej roli wewnątrzkomórkowego stężenia proliny w nierozpoznanym dotychczas mechanizmie jej udziału w PRODH/POX-zależnym procesie apoptozy/autofagii. W toku prowadzonych badań sprawdzono wpływ wybranych związków wpływających na dostępność wolnej proliny oraz związków pochodzenia naturalnego (betuliny i 28-O-propylbetuliny oraz polifenoli propolisu) na proces indukcji PRODH/POX zależnej apoptozy w komórkach gruczolakoraka endometrium oraz raka płaskonabłonkowego (CAL-27). Wyniki badań sugerują, że zarówno betulina i jej pochodna oraz polifenole propolisu indukują PRODH/POX-zależną apoptozę w komórkach nowotworowych.
W cyklu prac stanowiących efekt realizacji niniejszego projektu badawczego przedstawiamy nową strategię eksperymentalnej indukcji apoptozy polegającej na zahamowaniu biosyntezy kolagenu, zwiększeniu stężenia proliny w cytoplazmie oraz jej utylizacji w mitochondriach przy udziale PRODH/POX. Przeprowadzone badania sugerują, że wysoka aktywność PRODH/POX sprzyja indukcji apoptozy, podczas gdy niska aktywność PRODH/POX promuje pro-przeżyciowe szlaki metaboliczne (autofagię) w komórkach nowotworowych. Wnioski te stały się podstawą kolejnych hipotez doskonalenia strategii terapii przeciwnowotworowej poprzez nasilenie indukcji ekspresji PRODH/POX w komórce nowotworowej. Badania te poszerzają wiedzę dotyczącą znaczenia PRODH/POX i proliny oraz skutków zaburzenia utylizacji tego aminokwasu w komórce. Realizacja tego projektu zaowocowała również nawiązaniem współpracy z wybitnymi naukowcami z Włoch i USA.
- Zareba I, Palka J: Prolidase-proline dehydrogenase/proline oxidase/collagen biosynthesis axis as a potential interface of apoptosis/autophagy. Biofactors 2016;42:341-348.
- Szoka L, Karna E, Hlebowicz-Saratb K, Karaszewski J, Boryczka S, Palka J: Acetylenic derivative of betulin induces apoptosis in endometrial adenocarcinoma cell line. Biomedicine & Pharmacotherapy 2017;95:429–436.
- Zareba I, Surazynski A, Chrusciel M, Miltyk W, Doroszko M, Rahman N, Palka J: Functional Consequences of Intracellular Proline Levels Manipulation Affecting PRODH/POX-Dependent Pro-Apoptotic Pathways in a Novel in Vitro Cell Culture Model. Cellular Physiology and Biochemistry 2017;43:670-684.
- Zareba I, Celinska-Janowicz K, Surazynski A, Miltyk W, Palka J: Silencing Proline Oxidase directs proline-dependent pro-survival pathways in MCF-7 cells. Oncotarget 2018, doi.org/10.18632/oncotarget.24466.
- Celinska-Janowicz K, Zareba I, Lazarek U, Teul U, Tomczyk M, Palka J, Miltyk W: Constituents of propolis: chrysin, caffeic acid, p-coumaric acid, and ferulic acid induce PRODH/POX-dependent. Frontiers in Pharmacology 2018;9:336, 3 pp.
Identyfikacja mechanizmu przeciwnowotworowego działania metforminy, jako eksperymentalny kierunek doskonalenia farmakoterapii raka (2017/25/B/NZ7/02183). Uniwersytet Medyczny w Białymstoku.
Metformina stanowi aktualnie lek pierwszego rzutu w leczeniu cukrzycy typu II. Przypuszczenie o przeciwnowotworowym działaniu metforminy zainicjowały badania farmako-epidemiologiczne w 2005 roku wykazujące obniżone ryzyko choroby nowotworowej u pacjentów z cukrzycą typu II, przyjmujących metforminę. Aktualnie prowadzone są liczne badania doświadczalne i kliniczne w tym zakresie. Niemniej jednak molekularny mechanizm działania przeciwnowotworowego metforminy nie jest nadal znany.
Jednym z efektów działania metforminy jest aktywacja AMP kinazy (AMPK). Kiedy stosunek AMP/ATP wzrasta AMPK ulega aktywacji w celu przywrócenia prawidłowego poziomu ATP oraz hamuje wydatki energetyczne komórki związane między innymi z proliferacją komórek. AMPK podlega zatem regulacji szczególnie w warunkach niedoboru energetycznego (np. podczas głodzenia), a także hipoksji (podczas zmniejszonej ilości tlenu). Z jednej strony, AMPK hamuje procesy anaboliczne, z drugiej pobudza katabolizm. Jednym z substratów energetycznych w warunkach niedoboru glukozy jest prolina, pochodząca z produktów degradacji białek, głównie kolagenu. Prolina ulega degradacji w mitochondriach jedynie przez dehydrogenazę prolinową/oksydazę prolinową (PRODH/POX). Szczególnie interesująca w tym kontekście jest obserwacja indukcji PRODH/POX przez AMPK. Głównym procesem utylizacji proliny jest biosynteza kolagenu, która może ograniczać dostępność proliny do jej degradacji w mitochondriach. Z drugiej strony, aktywność prolidazy (enzym uwalniający prolinę z imidodipeptydów) jest ważnym regulatorem stężenia wolnej proliny w cytoplazmie.
PRODH/POX jest mitochondrialnym enzymem katalizującym konwersję proliny do kwasu pirolidyno-5-karboksylowego (P5C). Podczas konwersji proliny do P5C, elektrony są transportowane do łańcucha oddechowego produkując ATP lub generują ROS. W pierwszym przypadku, aktywacja PRODH/POX prowadzi do produkcji ATP dostarczając energii i służąc przeżyciu, w drugim przypadku ROS indukuje apoptozę. Jakkolwiek mechanizm przełączania funkcji PRODH/POX z hamującej na pobudzającą wzrost komórek nowotworowych nie jest znany to jednak wydaje się prawdopodobne, że w tym procesie ważną rolę może odgrywać dostępność proliny do tego procesu. Powyższe argumenty świadczą o potencjalnie ważnej roli proliny w mechanizmie regulacji apoptozy/autofagii.
Powiązanie AMPK, PRODH/POX i proliny z procesem apoptozy/autofagii w komórkach nowotworowych oraz stymulujące działanie metforminy na AMPK pozwala na przedstawienie hipotezy o mechanizmie udziału metforminy w apoptozie/autofagii. Kluczowe znaczenie w tym procesie może odgrywać wewnątrzkomórkowe stężenie proliny i jej konwersja do P5C. Z tego względu metabolizm proliny może odgrywać ważną rolę w regulacji apoptozy/autofagii. Może on być regulowany poprzez niektóre czynniki wzrostowe i transkrypcyjne np. HIF-1α, NF-κB.
Celem projektu badawczego jest identyfikacja mechanizmu przeciwnowotworowego działania metforminy jako induktora apoptozy w komórkach raka piersi poprzez analizę ekspresji niektórych receptorów, czynników transkrypcyjnych, białek sygnałowych, AMPK, PRODH/POX, oraz markerów apoptozy i autofagii w warunkach regulowanej dostępności proliny.
W celu realizacji projektu zostaną uzyskane klony komórek linii raka piersia MCF-7 z modyfikowaną ekspresją PRODH/POX i prolidazy. Następnie zostanie oceniony wpływ metforminy na niektóre procesy metaboliczne. Planowana jest ocena wpływu metforminy na proliferację komórek, biosyntezę kolagenu, ekspresję niektórych receptorów, czynników wzrostowych, białek szlaków sygnałowych oraz czynników transkrypcyjnych przy użyciu techniki RT-qPCR oraz Western immunoblot, immunocytochemicznych z wykorzystaniem mikroskopii konfokalnej oraz cytometrii przepływowej. W końcowym etapie badań zostanie wykonana analiza metabolomiczna oceniająca wpływ metforminy na profil aminokwasowy komórek MCF-7 z modyfikowaną ekspresją PRODH/POX.
Efekty biologiczne stosowania metforminy na komórki raka piersi ocenione zostaną w odniesieniu do potencjalnego wykorzystania i opracowania nowego molekularnego celu farmakoterapii raka. Poznanie mechanizmu przeciwnowotworowego działania metforminy pozwoli na doskonalenie farmakoterapii choroby nowotworowej.
Efekty realizacji projektu badawczego:
- Huynh Thi Yen Ly, Zaręba Ilona, Baszanowska Weronika, Lewoniewska Sylwia, Pałka Jerzy. Understanding the role of key amino acids in regulation of proline dehydrogenase/proline oxidase (prodh/pox)-dependent apoptosis/autophagy as an approach to targeted cancer therapy. Molecular and Cellular Biochemistry, 2020, 466, s. 35-44; Impact Factor: 3.396, Punktacja MEiN: 70.000, DOI: 10.1007/s11010-020-03685-y.
- Patent: Dwuniciowy kwas nukleinowy do wyciszania ekspresji genu kodującego białko PRODH/POX i jego zastosowania, wektor ekspresyjny, komórka gospodarza, klon komórkowy, kompozycja farmaceutyczna, sposób in vitro wyciszania ekspresji genu kodującego białko PRODH/POX, jednoniciowy kwas nukleinowy do wyciszania ekspresji genu kodującego białko PRODH/POX i jego zastosowania. Przyznane patenty nr 240375, nr 240376, nr 239994.
- Karna Ewa, Szoka Łukasz Marek, Huynh Thi Yen Ly, Pałka Jerzy. Proline-dependent regulation of collagen metabolism. Cellular and Molecular Life Sciences 2020 : 77, 10, s. 1911-1918, Impact Factor: 9.261, Punktacja MEiN: 140.000, DOI: 10.1007/s00018-019-03363-3.
- Pałka Jerzy, Ościłowska Ilona, Szoka Łukasz Marek. Collagen metabolism as a regulator of proline dehydrogenase/proline oxidase-dependent apoptosis/autophagy. Amino Acids, 2021, 9 pp; Impact Factor: 3.520; Punktacja MEiN: 100.000, DOI: 10.1007/s00726-021-02968-y.
- Zaręba Ilona, Huynh Thi Yen Ly, Kazberuk Adam, Teul Joanna, Klupczyńska Agnieszka, Matysiak Jan, Surażyński Arkadiusz, Pałka Jerzy. Overexpression of prolidase induces autophagic death in MCF-7 breast cancer cells. Cellular Physiology and Biochemistry, 2020, 54, 875-887; Punktacja MEiN: 140.000, DOI: 10.33594/000000275.
- Ościłowska Ilona, Huynh Thi Yen Ly, Baszanowska Weronika, Prokop Izabela, Surażyński Arkadiusz, Galli Mauro, Zabielski Piotr, Pałka Jerzy. Proline oxidase silencing inhibits p53-dependent apoptosis in MCF-7 breast cancer cells. Amino Acids, 2021, 14 pp; Impact Factor: 3.520, Punktacja MEiN: 100.000, DOI: 10.1007/s00726-021-03013-8.
- Klupczyńska Agnieszka, Misiura Magdalena, Miltyk Wojciech, Ościłowska Ilona, Pałka Jerzy, Kokot Zenon, Matysiak Jan. Development of an LC-MS targeted metabolomics methodology to study proline metabolism in mammalian cell cultures. Molecules, 2020: 25, 20, 13 pp, Article ID 4639; Impact Factor: 4.411, Punktacja MEiN: 140.000, DOI: 10.3390/molecules25204639.
- Huynh Thi Yen Ly, Ościłowska Ilona, Saiz Jorge, Nizioł Magdalena, Baszanowska Weronika, Barbas Coral, Pałka Jerzy. Metformin treatment or PRODH/POX-knock out similarly induces apoptosis by reprograming of amino acid metabolism, TCA, urea cycle and pentose phosphate pathway in MCF-7 breast cancer cells. Biomolecules 2021 : 11, 12, 21 pp, Article ID 1888; Impact Factor: 4.879; Punktacja MEiN: 100.000, DOI: 10.3390/biom11121888
- Huynh Thi Yen Ly, Ościłowska Ilona, Szoka Łukasz, Piktel Ewelina, Baszanowska Weronika, Bielawska Katarzyna, Bucki Robert, Miltyk Wojciech, Pałka Jerzy. Metformin induces PRODH/POX-dependent apoptosis in breast cancer cells. Frontiers in Molecular Biosciences 2022, 9, 11 pp, Article ID 869413, Impact Factor: 5.246, Punktacja MNiSW: 140.000, DOI: 10.3389/fmolb.2022.869413
- Ościłowska Ilona, Rółkowski Karol, Baszanowska Weronika, Huynh Thi Yen Ly, Lewoniewska Sylwia, Nizioł Magdalena, Sawicka Magdalena, Bielawska Katarzyna, Szoka Paweł, Miltyk Wojciech, Pałka Jerzy. Proline dehydrogenase/proline oxidase (PRODH/POX) is involved in the mechanism of metformin-induced apoptosis in C32 melanoma cell line. International Journal of Molecular Sciences 2022 : 23, 4, 15 pp., Article ID: 2354 Impact Factor: 5.924, Punktacja MEiN: 140.000, DOI: 10.3390/ijms23042354
- Rozprawa doktorska: Karol Rółkowski - Wpływ metforminy na proces POX-zależnej apoptozy/autofagii w komórkach czerniaka C32. Publiczna obrona rozprawy doktorskiej: 30.06.2022
- Rozprawa doktorska: Thi Yen Ly Huynh - Metabolomic approach to understand the mechanism of metformin-induced PRODH/POX-dependent apoptosis in MCF-7 breast cancer cells. Rozprawa doktorska złożona: 28.04.2022
- Rozprawa habilitacyjna: Ilona Ościłowska (Zaręba) – Mechanizmy regulujące PRODH/POX-zależną apoptozę w komórkach raka piersi MCF-7. Rozprawa hablilitacyjna złożona do Rady Doskonałości Naukowej: 28.01.2022
Rola estrogenów w regulacji PRODH/POX-zależnej apoptozy/autofagii w komórkach raka piersi MCF7 (2017/27/N/NZ7/01770). Uniwersytet Medyczny w Białymstoku
Estrogeny, zwłaszcza estradiol stanowią ważny regulator proliferacji, przeżycia i różnicowania komórek w różnych tkankach. Jednym z metabolitów estradiolu jest 2-metoxyestradiol (MOE), który hamuje proliferację komórek w różnych typach nowotworów. Ważną funkcją estrogenów jest regulacja metabolizmu tkanki łącznej. Estradiol pobudza obrót kolagenu poprzez nasilenie biosyntezy i degradacji tego białka. Wskaźnikiem tego procesu jest wzrost aktywności prolidazy (enzymu uwalniającego prolinę z połączeń imidopeptydowych do resyntezy kolagenu).
PRODH/POX jest mitochondrialnym enzymem katalizującym konwersję proliny do kwasu pirolidyno-5-karboksylowego (P5C). Podczas konwersji proliny do P5C, elektrony są transportowane do łańcucha oddechowego produkując ATP lub generują reaktywne formy tlenu (ROS). W pierwszym przypadku, aktywacja PRODH/POX prowadzi do produkcji ATP dostarczając energii i służąc przeżyciu, w drugim przypadku ROS indukują apoptozę. Mechanizm przełączania funkcji PRODH/POX z hamującej na pobudzającą wzrost komórek nowotworowych nie jest znany. Prawdopodobnie dostępność proliny do tego procesu może odgrywać ważną rolę w mechanizmie regulacji apoptozy/autofagii.
Powiązanie estrogenów, PRODH/POX i metabolizmu proliny z procesem apoptozy/autofagii w komórkach nowotworowych pozwala na przedstawienie hipotezy o roli estradiolu i jego metabolitu, MOE, w regulacji molekularnego mechanizmu PRODH/POX-zależnej apoptozy/autofagii. Kluczowe znaczenie w tym procesie może odgrywać wzrost stężenia proliny w cytoplazmie przyczyniając się do indukcji apoptozy w komórkach nowotworowych poprzez aktywację kaskady ścieżek sygnałowych obejmujących PRODH/POX oraz niektóre czynniki transkrypcyjne.
Celem projektu badawczego jest zweryfikowanie hipotezy zakładającej, że aktywacja receptora estrogenowego pobudza metabolizm proliny (wzrost biosyntezy kolagenu i utylizacji proliny w tym procesie) prowadząc do obniżenia ilości wolnej proliny (jako substratu do PRODH/POX zależnej apoptozy) oraz kreuje pro-przeżyciowy fenotyp komórki raka piersi MCF-7. Natomiast metabolit estradiolu, MOE, poprzez upośledzenie biosyntezy kolagenu prowadzi do wzrostu stężenia wewnątrzkomórkowej proliny indukując PRODH/POX-zależną apoptozę. Upośledzenie funkcji receptora estrogenowego poprzez MOE powinno zatem przyczynić się do indukcji pro-apoptotycznego fenotypu komórki.
W celu realizacji projektu zostaną uzyskane klony komórek linii raka piersi MCF-7 z modyfikowaną ekspresją PRODH/POX. Następnie zostanie oceniony wpływ estradiolu i jego metabolitu (MOE) na niektóre procesy metaboliczne tych komórek. Planowana jest ocena wpływu metforminy na proliferację komórek, biosyntezę kolagenu, aktywność prolidazy, ekspresję PRODH/POX, niektórych czynników transkrypcyjnych, receptorów czynników wzrostowych oraz białek szlaków sygnałowych przy użyciu techniki RT-qPCR, Western immunoblot oraz immunocytochemii przy wykorzystaniu mikroskopii konfokalnej oraz cytometrii przepływowej. Oceniony zostanie również wpływ estradiolu i MOE na cykl komórkowy. W końcowym etapie badań zostanie wykonana analiza metabolomiczna aminokwasów przy użyciu wysokosprawnej chromatografii cieczowej lub chromatografii gazowej sprzężonej ze spektrometrem mas (LC-QTOF-MS/GC-MS), oceniająca wpływ estradiolu i MOE na profil aminokwasowy komórek MCF-7 z modyfikowaną ekspresją PRODH/POX.
Projekt ten ma na celu wyjaśnienie wpływu estradiolu i jego metabolitu (MOE) na poziomie molekularnym na PRODH/POX-zależną apoptozę lub autofagię w eksperymentalnym modelu raka piersi. Efekty biologiczne stosowania estrogenów i MOE na komórki raka piersi ocenione zostaną w odniesieniu do potencjalnego wykorzystania i opracowania nowego molekularnego celu farmakoterapii raka. Poznanie molekularnego wpływu estradiolu i MOE na PRODH/POX-zależną apoptozę/autofagię pozwoli na doskonalenie farmakoterapii choroby nowotworowej. Udokumentowanymi wynikami projektu badawczego będą publikacje naukowe w czasopismach o wysokim współczynniku wpływu oraz referaty wygłaszane na krajowych i międzynarodowych konferencjach naukowych.
Efekty realizacji projektu badawczego:
- Lewoniewska Sylwia, Ościłowska Ilona, Forlino Antonella, Pałka Jerzy. Understanding the role of estrogen receptor status in PRODH/POX-dependent apoptosis/survival in breast cancer cells. Biology 2021: 10, 12, 15 pp, Article ID 1314; Impact Factor: 5.079; Punktacja MEiN: 100.000, DOI: 10.3390/biology10121314
- Lewoniewska Sylwia, Ościłowska Ilona, Huynh Thi Yen Ly, Prokop Izabela, Baszanowska Weronika, Bielawska Katarzyna, Pałka Jerzy. Troglitazone-induced PRODH/POX-dependent apoptosis occurs in the absence of estradiol or ERβ in ER-negative breast cancer cells. Journal of Clinical Medicine 2021: 10, 20, 18 pp., Article ID: 4641; Impact Factor: 4.242; Punktacja MEiN: 140.000, DOI: 10.3390/jcm10204641.
- Ościłowska Ilona, Huynh Thi Yen Ly, Baszanowska Weronika, Prokop Izabela, Surażyński Arkadiusz, Galli Mauro, Zabielski Piotr, Pałka Jerzy. Proline oxidase silencing inhibits p53-dependent apoptosis in MCF-7 breast cancer cells. Amino Acids, 2021, 14 pp; Impact Factor: 3.520, Punktacja MEiN: 100.000, DOI: 10.1007/s00726-021-03013-8.
- Rozprawa doktorska: Sylwia Lewoniewska – The role of estrogen receptor status in proline dehydrogenase/proline oxidase-dependent apoptosis in breast cancer cells. Rozprawa doktorska złożona: 13.06.2022
- Rozprawa habilitacyjna: Ilona Ościłowska (Zaręba) – Mechanizmy regulujące PRODH/POX-zależną apoptozę w komórkach raka piersi MCF-7. Rozprawa hablilitacyjna złożona do Rady Doskonałości Naukowej: 28.01.2022